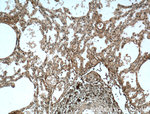
OGN Antibody in Immunohistochemistry (Paraffin) (IHC (P))
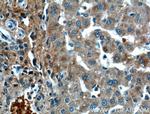
OGN Antibody in Immunohistochemistry (Paraffin) (IHC (P))

Search
Proteintech
OGN Monoclonal Antibody (2A5F11)
{{$productOrderCtrl.translations['antibody.pdp.commerceCard.promotion.promotions']}}
{{$productOrderCtrl.translations['antibody.pdp.commerceCard.promotion.viewpromo']}}
{{$productOrderCtrl.translations['antibody.pdp.commerceCard.promotion.promocode']}}: {{promo.promoCode}} {{promo.promoTitle}} {{promo.promoDescription}}. {{$productOrderCtrl.translations['antibody.pdp.commerceCard.promotion.learnmore']}}
产品信息
66382-1-IG
种属反应
宿主/亚型
分类
类型
克隆号
抗原
偶联物
形式
浓度
规格
纯化类型
保存液
内含物
保存条件
运输条件
产品详细信息
Immunogen sequence: MKTLQSTLL LLLLVPLIKP APPTQQDSRI IYDYGTDNFE ESIFSQDYED KYLDGKNIKE KETVIIPNEK SLQLQKDEAI TPLPPKKEND EMPTCLLCVC LSGSVYCEEV DIDAVPPLPK ESAYLYARFN KIKKLTAKDF ADIPNLRRLD FTGNLIEDIE DGTFSKLSLL EELSLAENQL LKLPVLPPKL TLFNAKYNKI KSRGIKANAF KKLNNLTFLY LDHNALESVP LNLPESLRVI HLQFNNIASI TDDTFCKAND TSYIRDRIEE IRLEGNPIVL GKHPNSFICL KRLPIGSYF (1-298 aa encoded by BC037273 )
靶标信息
Mimecan induces ectopic bone formation in conjunction with transforming growth factor beta. Mimecan is a small proteoglycan which contains tandem leucine-rich repeats. Mimecan is encoded by the OGN gene, a member of the small leucine-rich proteoglycan (SLRP) family of proteins. Mimecan induces ectopic bone formation in conjunction with transforming growth factor beta (TGF-beta-1 or TGF-beta-2) and may regulate osteoblast differentiation. High expression of mimecan protein may be associated with elevated heart left ventricular mass. Alternative splicing results in multiple transcript variants of mimecan. Alternatively spliced transcript variants that encode mimecan have been found.
仅用于科研。不用于诊断过程。未经明确授权不得转售。
篇参考文献 (0)
生物信息学
蛋白别名: corneal keratan sulfate proteoglycan; MCN; small leucine-rich proteoglycan; Mimecan; mimecan proteoglycan; OGN; OIF; Osteoglycin; osteoglycin/mimecan; Osteoinductive factor; unnamed protein product
基因别名: OG; OGN; OIF; SLRR3A
UniProt ID: (Human) P20774
Entrez Gene ID: (Pig) 106509723, (Human) 4969